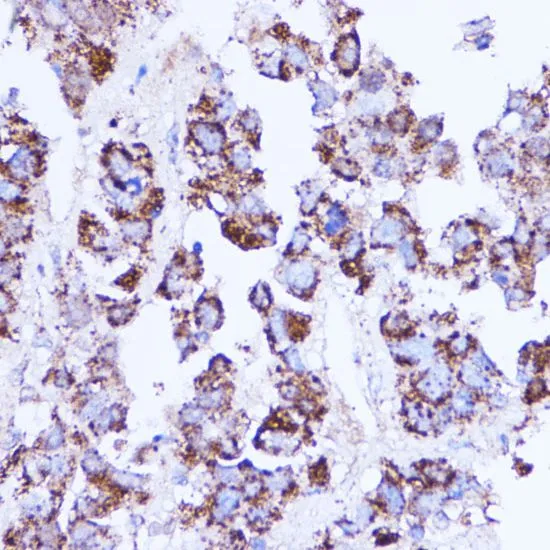

ICC/IF analysis of L929 cells using GTX64542 SHMT2 antibody. Blue : DAPI Dilution : 1:100
SHMT2 antibody
GTX64542
ApplicationsImmunoFluorescence, ImmunoPrecipitation, Western Blot, ImmunoCytoChemistry, ImmunoHistoChemistry, ImmunoHistoChemistry Paraffin
Product group Antibodies
ReactivityHuman, Mouse, Rat
TargetSHMT2
Overview
- SupplierGeneTex
- Product NameSHMT2 antibody
- Delivery Days Customer9
- Application Supplier NoteWB: 1:500 - 1:2000. ICC/IF: 1:50 - 1:200. IHC-P: 1:50 - 1:200. IP: 1:50 - 1:200. *Optimal dilutions/concentrations should be determined by the researcher.Not tested in other applications.
- ApplicationsImmunoFluorescence, ImmunoPrecipitation, Western Blot, ImmunoCytoChemistry, ImmunoHistoChemistry, ImmunoHistoChemistry Paraffin
- CertificationResearch Use Only
- ClonalityPolyclonal
- ConjugateUnconjugated
- Gene ID6472
- Target nameSHMT2
- Target descriptionserine hydroxymethyltransferase 2
- Target synonymsGLYA, HEL-S-51e, NEDCASB, SHMT, mSHMT, serine hydroxymethyltransferase, mitochondrial, GLY A+, epididymis secretory sperm binding protein Li 51e, glycine auxotroph A, human complement for hamster, glycine hydroxymethyltransferase, mitochondrial serine hydroxymethyltransferase, serine aldolase, serine hydroxymethylase, serine hydroxymethyltransferase 2 (mitochondrial), serine methylase, threonine aldolase
- HostRabbit
- IsotypeIgG
- Protein IDP34897
- Protein NameSerine hydroxymethyltransferase, mitochondrial
- Scientific DescriptionThis gene encodes the mitochondrial form of a pyridoxal phosphate-dependent enzyme that catalyzes the reversible reaction of serine and tetrahydrofolate to glycine and 5,10-methylene tetrahydrofolate. The encoded product is primarily responsible for glycine synthesis. The activity of the encoded protein has been suggested to be the primary source of intracellular glycine. The gene which encodes the cytosolic form of this enzyme is located on chromosome 17. Alternative splicing results in multiple transcript variants. [provided by RefSeq, Oct 2009]
- ReactivityHuman, Mouse, Rat
- Storage Instruction-20°C or -80°C,2°C to 8°C
- UNSPSC12352203